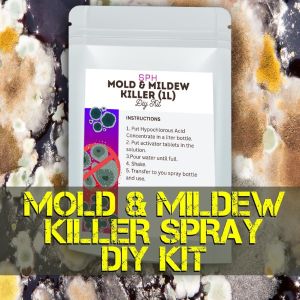
SPH MOLD & MILDEW KILLER DIY KIT (1L)

SPH MOLD & MILDEW KILLER DIY KIT (1L)

SPH MOLD & MILDEW KILLER DIY KIT (1L)
BritePH

BritePH
Seller ratings 98%
Review
5.0
/5
9 Ratings
C
C****a
Dec 11, 2025
Effective mold removal, Kills 99.9% bacteria, Fresh clean scent, Perfect for kitchens, Effective mold removal,
Helpful (0)
S
S****o
Oct 07, 2025
Perfect for kitchens, That said, some studies suggest it may offer some benefits, including killing bacteria, lowering blood sugar levels, and promoting weight loss.\n\nApple cider vinegar appears safe when diluted as long as you don’t take excessive amounts of it.
Helpful (0)
You May Also Like

00:50
300pcs 28.5x29.5cm Burger Wrapper Food Liner GreaseProof Generic Print Food Sandwich Wax Paper Food Liner Baking Wrapper

00:34
Fabric Rust Stain Remover Multi-purpose Clothes Cleaner Waterless Clothing Cleansing Agent 250ml

00:38
Slim Trash Can with Lid Soft Close Stainless Steel 7L/9L/13L Bathroom Garbage Can with Inner Bucket

00:10
CHEMSTORE Ink Cleaner Stain Remover: A Comprehensive Guide

00:45
100g Powerful Sink Drain Cleaner High Efficiency Clog Remover Kitchen Sewer Power Pipe Channel Powder Cleaning Tools

00:17
Toilet Cleaner Stick Effective Concentrated Descaling Toilet Cleaning Stick Automatic Toilet Cleaner

00:54
Disposable White Box Series 880cc: A Comprehensive Guide

00:15
Glade Authentic Fresh Room Air Freshener Spray 300 mL Odor Eliminator Sensual Sandalwood Pure Clean Linen Relaxing Zen

00:12
Food-grade silicone material compartmentalized lidless lunch box food storage mold - 2 compartments / 3 compartments

00:10
Target Multi-Insect Killer by Personal Collection

00:57
Yexuan Bulk 5kg Tissue Napkins Hygienic Restaurant Hotel Banquet Home Affordable Packaged Three-layer Drawn Paper Towels

00:19